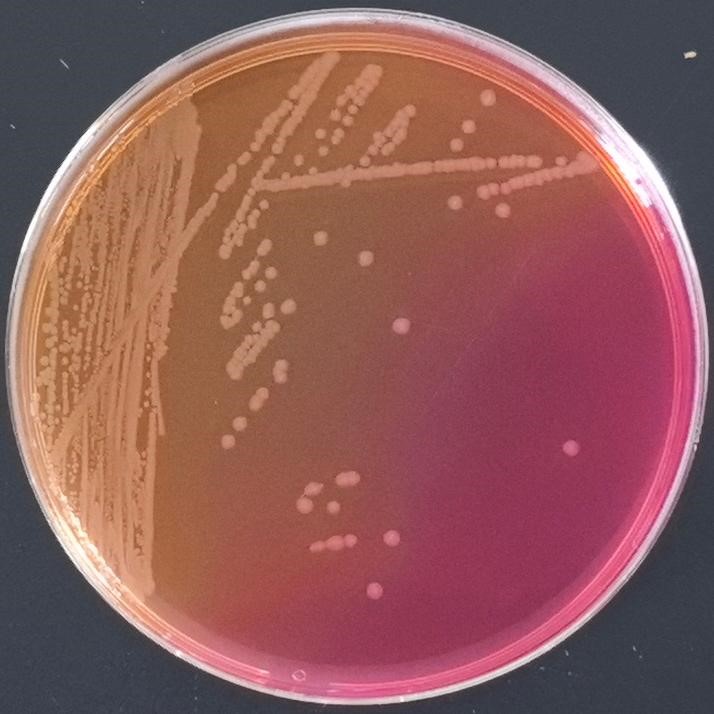
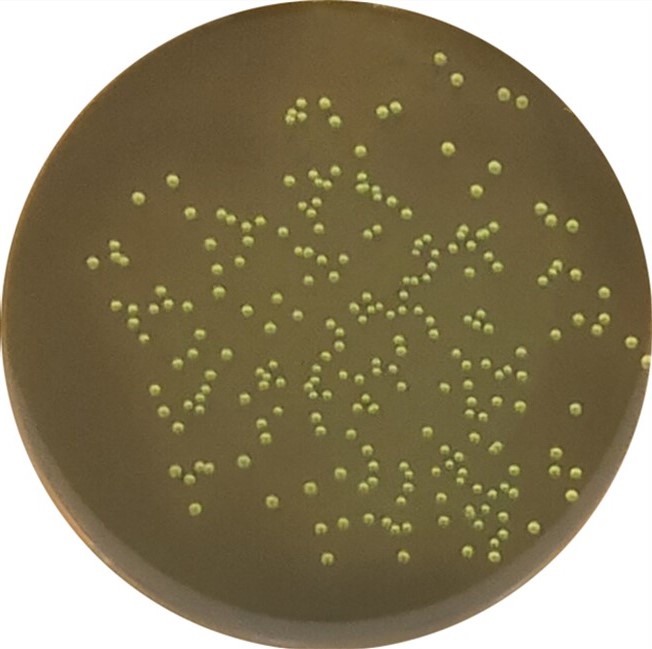

海博微信公众号
海博微信公众号
 海博天猫旗舰店
海博天猫旗舰店


 海博微信公众号
海博微信公众号
 海博天猫旗舰店
海博天猫旗舰店




糖类作为微生物生长代谢的核心碳源与能源物质,其分解利用能力是微生物分类鉴定、代谢机制研究及工业应用开发的重要依据。微生物在酶系催化作用下对糖类进行氧化、发酵等代谢反应,会产生有机酸、醇类、醛酮类等产物,这些产物与特定显色试剂发生化学反应,形成特征性颜色变化,即微生物利用糖类后的颜色反应。此类反应具有特异性强、操作简便、结果直观等优势,广泛应用于微生物学研究、食品检测、临床诊断及环境监测等领域。
一、微生物利用糖类颜色反应的核心机制
微生物对糖类的代谢途径具有多样性,核心差异在于是否需要氧气参与及代谢产物的种类,而颜色反应的本质是代谢产物与显色剂的特异性化学反应。微生物体内存在丰富的糖代谢酶系,如淀粉酶、糖苷酶、脱氢酶等,这些酶类可催化不同糖类发生水解、氧化、发酵等反应,产生具有特定化学性质的中间产物或终产物。
有氧代谢中,微生物通过糖酵解、三羧酸循环等途径将糖类彻底氧化分解为二氧化碳和水,部分微生物可在代谢过程中产生还原性物质(如NADH、NADPH),这些物质能还原显色剂中的金属离子(如铁离子、铜离子),引发颜色变化。无氧发酵过程中,微生物则将糖类转化为有机酸(乳酸、乙酸、丙酮酸等)、醇类(乙醇、丙醇)、酮类(丙酮)等产物,其中有机酸可改变反应体系的pH值,促使酸碱指示剂发生颜色转变;醇类、酮类则可与特定试剂发生氧化还原反应或加成反应,形成特征颜色。
此外,部分微生物可产生特异性酶类,仅能催化特定糖类发生反应,使得颜色反应具有菌株特异性,这也是通过颜色反应进行微生物分类鉴定的核心原理。
二、微生物利用糖类的常见颜色反应类型及特征
1、基于酸碱指示剂的颜色反应
此类反应是微生物发酵糖类最常见的颜色变化形式,核心是发酵产物(有机酸)改变培养基pH值,触发酸碱指示剂的颜色转变。常用酸碱指示剂包括酚红、溴甲酚紫、中性红等,不同指示剂的变色范围与颜色差异不同,适用于不同发酵类型的检测。
在实际应用中,麦康凯琼脂培养基就利用了这一原理,其含乳糖和中性红指示剂,大肠埃希氏菌发酵乳糖产酸导致pH下降,菌落呈粉红色或红色,周围培养基也可能变红;而沙门氏菌、志贺氏菌等不发酵乳糖的肠道致病菌,菌落则为无色或淡黄色,如图1所示,可初步区分乳糖发酵菌与非发酵菌。

图1 麦康凯琼脂上大肠埃希氏菌(左)及沙门氏菌(右)的生长结果
中国蓝琼脂培养基含乳糖、中国蓝和玫红酸指示剂,酸性环境下中国蓝显色,乳糖发酵菌落呈蓝色,非发酵菌落为淡红色或无色,如图2所示,进一步丰富了酸碱指示剂类反应的应用场景。

图2 中国蓝琼脂上大肠埃希氏菌(a)及沙门氏菌(b)的生长结果
2、基于还原性产物的颜色反应
微生物在糖类代谢过程中产生的还原性物质(如NADH、葡萄糖酸、麦芽糖等),可与特定显色剂发生氧化还原反应,形成特征颜色。此类反应常用于微生物代谢能力的精准鉴定,尤其适用于区分代谢途径相似的菌株。
糖发酵试验中的班氏试剂反应是典型代表,班氏试剂由硫酸铜、柠檬酸钠等组成,在碱性条件下可与还原性糖(如葡萄糖、麦芽糖)发生反应,生成砖红色的氧化亚铜沉淀。该反应可用于检测微生物是否能将糖类转化为还原性产物。
此外,TTC(氯化三苯基四氮唑)还原试验也属于此类反应,TTC为无色可溶性物质,可被微生物代谢产生的还原性物质还原为红色不溶性的三苯基甲臜(TPF),通过颜色深浅可判断微生物的代谢活性,代谢能力越强,颜色越鲜艳,常用于微生物计数及活力检测。
3、基于特异性酶解产物的颜色反应
部分微生物可产生特异性糖苷酶,仅能催化特定糖类的糖苷键断裂,产生具有显色反应活性的产物,此类反应具有高度特异性,是微生物分类鉴定的重要依据。
常见的特异性酶解颜色反应包括β-半乳糖苷酶试验、淀粉水解试验等。β-半乳糖苷酶试验(ONPG试验)常用于区分大肠埃希氏菌与产气肠杆菌等肠道菌群。ONPG(邻硝基苯基-β-D-半乳糖苷)为无色底物,大肠埃希氏菌产生的β-半乳糖苷酶可将其水解为邻硝基酚(黄色)和半乳糖,通过观察培养基是否变黄可判断菌株是否具有该酶活性;而产气肠杆菌虽能发酵乳糖,但β-半乳糖苷酶活性极低,ONPG试验呈阴性,无颜色变化,如图3所示。

图3 ONPG试验现象
淀粉水解试验中,微生物产生的淀粉酶可将淀粉分解为麦芽糖、葡萄糖等小分子糖类,淀粉与碘液反应呈蓝色,而水解产物不与碘液显色,因此在接种微生物的淀粉培养基上滴加碘液后,若不变蓝,说明淀粉被水解,常用于枯草芽孢杆菌、放线菌等菌株的鉴定,如图4所示。

图4 淀粉水解培养基试验现象
三、不同微生物类群的特异性显色鉴定体系
1、肠道菌群鉴定的核心培养基与颜色反应
肠道杆菌科的鉴别高度依赖含糖培养基的显色结果,除麦康凯琼脂、中国蓝琼脂外,伊红美蓝琼脂、三糖铁琼脂、TCBS琼脂等也发挥着关键作用。
伊红美蓝琼脂含乳糖、伊红和美蓝,大肠埃希氏菌因强烈发酵乳糖产酸,染料在酸性环境下沉淀并浓缩,形成具有金属光泽的绿色菌落,鉴别力更强且能抑制部分革兰氏阳性菌生长;而沙门氏菌、志贺氏菌等不发酵乳糖,形成无色或淡粉色菌落。如图5所示。

图5 伊红美蓝培养基上大肠埃希氏菌(左)和沙门氏菌(右)的生长现象
三糖铁琼脂斜面含乳糖、蔗糖和葡萄糖,含酚红指示剂及硫酸亚铁(检测H2S)。沙门氏菌(非伤寒)表现为斜面红/底层黄、产气、变黑;志贺氏菌为斜面红/底层黄、不产气、不变黑;大肠埃希氏菌则为斜面黄/底层黄、产气,通过多重颜色与形态特征实现精准区分。如图6所示。

图6 三糖铁培养基微生物生长现象
TCBS琼脂专为弧菌设计,含蔗糖、胆盐、麝香草酚蓝和溴麝香草酚蓝指示剂,霍乱弧菌发酵蔗糖产酸,菌落呈黄色;副溶血性弧菌不发酵蔗糖,菌落呈蓝绿色,如图7所示,为弧菌的快速鉴定提供了有效手段。


图7 TCBS培养基上霍乱弧菌(左)和副溶血性弧菌(右)的生长现象
2、革兰氏阳性球菌鉴定的关键培养基
甘露醇氯化钠琼脂也是革兰氏阳性球菌鉴定的重要工具。甘露醇氯化钠琼脂含高浓度氯化钠、甘露醇和酚红指示剂,金黄色葡萄球菌可发酵甘露醇产酸,使菌落周围培养基变黄色,如图8所示;表皮葡萄球菌等不发酵甘露醇,培养基保持红色,实现了葡萄球菌属内的快速区分。

图8 金黄色葡萄球菌在甘露醇氯化钠培养基上的生长现象
3、其他重要鉴别与标准化系统
尿素琼脂斜面通过检测尿素酶活性鉴别微生物,含尿素和酚红,能快速分解尿素的细菌(如幽门螺杆菌、变形杆菌)使整个培养基由黄变紫红色,这是与沙门氏菌等尿素酶阴性菌株的重要鉴别点,如图9所示。

图9 尿素酶培养基上微生物的生长现象
四、产品展示
上述用到的产品主要有:
|
产品货号 |
产品名称 |
用途 |
|
HB6238 |
用于肠道致病菌的选择性分离培养 |
|
|
HB6233 |
弱选择性培养基,用于肠道致病菌的选择性分离 |
|
|
HB8783 |
用于检测是否还原糖 |
|
|
GS009 |
用于沙门氏菌和志贺氏菌、霍乱弧菌生化鉴定 |
|
|
HB8523 |
用于细菌淀粉酶试验 |
|
|
HB0107 |
弱选择性培养基,用于分离肠道致病菌,特别是大肠杆菌 |
|
|
HB4088-13 |
用于肠杆菌科细菌的生化反应筛选 |
|
|
HB4130 |
用于致病性弧菌的选择性分离 |
|
|
HB4128-22 |
用于金黄色葡萄球菌的选择性分离培养 |
|
|
HB4095 |
用于细菌脲酶检测试验 |
注:本文属海博生物原创,未经允许不得转载。
下一篇:没有了!
| 相关文章: | ||



